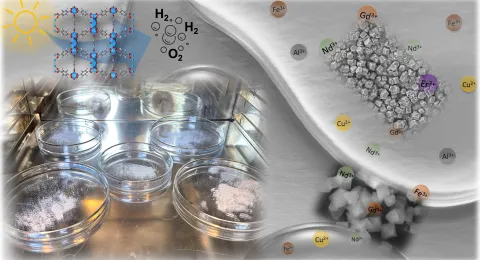
Metal-organic framework

Metal-organic-frameworks (MOFs) composed of metal centers and coordinating ligands are highly appealing materials for the wide range of applications due to their exceptional properties such as extremely high surface area and porosity and tunable structures. However, their applicability in practice has not been very easy because of the lack of stability and difficult handling of the fine powders. One of the ways to tackle these problems is to attach MOFs firmly on the solid substrates creating coatings or thin films that still maintain the important properties of MOFs. In this project the substrates will be produced by additive manufacturing/3D-printing in order to create optimal supports for MOF growth and finally the structures with adjusted and tailored properties for the target applications. The applications included in this project are emerging aqueous applications such as metal recovery, radionuclide removal, water adsorption, desalination, and catalytic wet oxidation. The main expected results are a) new significant evidence about the applicability of highly sophisticated MOF-functionalized 3D-materials in target applications, b) repeatable routes for growing stable MOF layers on the substrates composed of different materials, c) profound understanding the mechanisms related to the growth of MOFs and their possible structural changes, and d) deep knowledge about producing substrates by AM/3D-printing for separation and purification. Project has high scientific impact because for the first time systematic studies related to MOF growth on the 3D-substrates will be conducted in order to obtain materials targeted for specific applications. This will be also interesting for companies working in the related fields because benefits of the MOFs and 3D-substrates will be combined. This research plan is constructed by utilizing the expertise of applicant and her collaborative network. The aim is to strengthen the applicant’s research group and produce novel highlevel scientific results as well as solutions for practical applications.
Project funding:
Academy of Finland
Duration of the project:
1.9.2020-31.8.2025
Goals
- Produce water stable MOFs with tailored properties for target applications.
- Produce 3D substrates with optimized materials, structures and geometries.
- Grow stable MOF-coatings on the 3D-substrates without weakening the important properties of MOFs or supporting materials.
- Verify the applicability of the MOF-coated 3D-substrates in target applications.
Staff